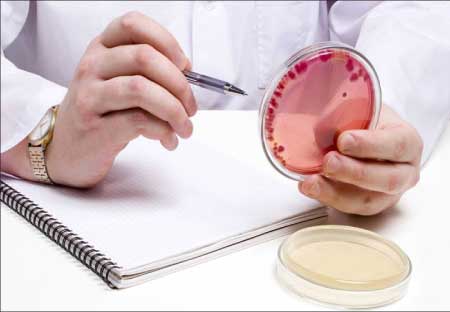
جريدة الحقيقة

الثوم قادر على التصدي لتسمم الكلى
أضافت دراسة مصرية صادرة عن المركز القومي للبحوث فائدة جديدة للثوم، وهو تأثيره في حماية الكلى من التسمم. وتوصلت دراسات سابقة إلى فعالية الثوم في تنظيم مستوى سكر الدم، واحتوائه على نسبة عالية من اليود، بما يجعله مفيداً بشكل كبير في الوقاية من مرض فرط نشاط الغدة...